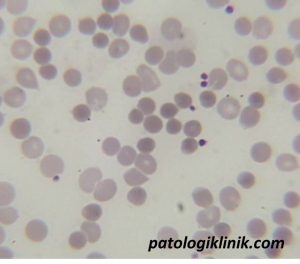
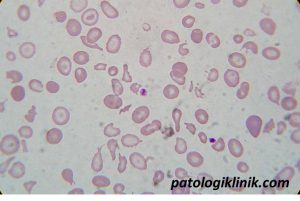

Aspek Laboratorium Anemia Hemolitik

Hemolisis, sesuai dengan namanya (hema=darah; lisis=pecah), adalah pemecahan dan/atau pembuangan eritrosit (sel darah merah) dari sirkulasi pembuluh darah lebih cepat dari normal (normal 120 hari). Gejala dan tanda yang sering muncul adalah anemia akibat perusakan eritrosit lebih cepat dari produksinya. Tanda lain yang bisa ditemukan adalah jaundice (sklera mata dan kulit kekuningan), batu empedu, atau peningkatan jumlah retikulosit.
Terdapat dua mekanisme hemolisis, yaitu hemolisis intravaskuler dan ekstravaskuler. Hemolisis intravaskuler (intra=di dalam; vaskuler=pembuluh darah) adalah perusakan eritrosit yang terjadi di dalam pembuluh darah, yang menyebabkan keluarnya isi eritrosit ke dalam plasma darah. Penyebabnya bisa karena adanya kerusakan endotel pembuluh darah, aktivasi komplemen darah, atau infeksi yang menyebabkan kerusakan membran sel secara langsung.
Hemolisis ekstravaskuler (ekstra=di luar; vaskuler=darah) adalah perusakan eritrosit yang terjadi di luar pembuluh darah, yaitu di makrofag limpa dan hati. Eritrosit normal dapat melewati limpa yang secara struktur berukuran kecil dan berbentuk seperti labirin dengan leluasa, sedangkan eritrosit yang memiliki kelainan struktur fisik dan adanya ikatan dengan antibodi tidak dapat melewatinya sehingga difagositosis dan dirusak oleh makrofag.
Secara umum, hasil laboratorium yang bisa ditemukan adalah:
- Kadar Hb yang turun (anemia). Anemia pada hemolisis sebagian besar adalah anemia normokrom normositik, walau bisa juga hipokrom mikrositik seperti pada thalassemia.
- Retikulosit; peningkatan kadar retikulosit (normal 1,5-2,5%), merupakan respon normal petanda peningkatan produksi eritrosit di sumsum tulang. Peningkatan retikulosit dapat dilihat dalam waktu 3-5 hari setelah turunnya Hb. Retikulosit pada apusan darah tepi bisa dideteksi dengan ditemukannya eritrosit yang berukuran besar dan berwarna kebiruan (polikromasi).
- Apusan darah tepi. Dari apusan darah tepi dapat ditemukan bermacam bentukan seperti sferosit, skistosit, polikromasi, sel target dan sel tear drop
Resume hasil laboratorium pada masing-masing penyebab anemia hemolitik adalah:
Penyakit Dapatan
- Immune-mediated (AIHA, keganasan, transfusi, drugs-induced, infeksi) –> sferosit pada apusan darah tepi dan direct Coomb’s test (+)
- Microangiopathic (TTP, HUS, DIC, eklamsia) –> skistosit pada apusan darah tepi
- Infeksi malaria –> tetes tebal dan tetes tipis, serologis

Herediter
- Ensimopati (defisiensi G6PD) –> pengukuran aktivitas G6PD rendah
- Membranopati (sferositosis herediter) –> sferosit pada apusan darah tepi, direct Coomb’s test (+), riwayat penyakit keluarga yang sama
- Hemoglobinopati (thalassemia, sickle cell disease) –> sel target dan skistosit pada apusan darah tepi, elektroforesis Hb, pemeriksaan genetik

Semoga Bermanfaat
Sumber:
Dhaliwal G, Cornett PA, and Tierney LM. 2004. Hemolytic Anemia. Am Fam Physician 69:2599-
2606




![[Download] Pedoman Nasional Pelayanan Kedokteran Tata Laksana Thalassemia (KMK)](/content/images/uploads/2022/10/KMK.jpg)
![[Download] Pemeriksaan Laboratorium pada Thalassemia](/content/images/uploads/2022/09/cover-web-scaled.jpg)